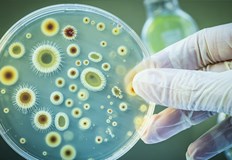
СЗО предупреждава за критична неподготвеност и нарастваща резистентност към лекарстваГъбични

... да приемат лекарствата си редовно, а възрастните хора трябва да приемат ваксини, препоръчани от техните лекари, за да намалят риска от белодробни инфекции", каза той.
Хора Света - Новини
Глобален преглед показва че 76 от населението не достига препоръчителния
...... на мазна риба (сьомга, скумрия) или чрез добавки.Но съществуват пречки:ниска консумация на рибаограничен достъп до добавкипритеснения за устойчивостта на рибните ресурсиЧетете още: Ябълки срещу банани
Община Нова Загора получи одобрение за финансиране на проект №
...... условия на живот. Модернизираната база, заедно с новите зелени технологии, ще направи услугата по-устойчива, по-ефективна и по-добра за хората, които имат най-голяма нужда от подкрепа.
Класация определи топ 10 на най богатите в света По традиция
...... САЩИзточник: GoogleИндустрия: Технологии9. Амансио Ортега - 89 г.Състояние: 124 млрд. долараДържава: ИспанияИзточник: ZaraИндустрия: Мода и търговия10. Стив Болмър - 69 г.Състояние: 118 млрд. долараДържава: САЩИзточник: MicrosoftИндустрия: Технологии
Съоснователят на GoogleСергей Брин влезе в тримата най богати хора в
...... човек в светас нетно състояние от 480.5 милиарда долара. Второто място е за съоснователя на Google Лари Пейдж с нетно състояние от 262.2 милиарда долара.
589 милиона възрастни по света живеят със захарен диабет –
...... благоприятна и приобщаваща работна среда“, обобщи изпълнителният директор на УСБАЛЕ „Акад. Иван Пенчев“ – София и член на УС на БДЕ проф. д-р Мария Орбецова.
7 от 10 възрастни с диабет са в трудоспособна възраст
...... да се преразгледат компенсаторните механизми, по които работи НЗОК, тъй като в момента те санкционират компаниите, които предлагат най-ефективните медикаменти и терапии", подчерта Деян Денев.
Българката отиде с инвалидната си количка на шоу на Тейлър
...... които мечтаят да бъдат част от радостта, която другите приемат за даденост. Историята ѝ стигна дори до огромните екрани на Таймс Скуеър в Ню Йорк.
Българката отиде с инвалидната си количка на шоу на Тейлър
...... които мечтаят да бъдат част от радостта, която другите приемат за даденост. Историята ѝ стигна дори до огромните екрани на Таймс Скуеър в Ню Йорк
На пръв поглед кореноплодът Маниока или по известна като cassava изглежда
...... храна, но и на условията на отглеждане и обработка, особено когато става дума за храни, разпространени в бедни райони с високи екологични и социални рискове.
Връзката е копирана Докато преглеждаше видеоклипове на пътешественици които работят
...... доброволец в семейна ферма за фъстъци близо до Пай, в северен Тайланд, когато е на 28 години.
В днешно време хората трябва да се опитват да останат
...... бъдат отгатнати, както и всякаква лична информация. actualno.com Още новини четете в: Бизнес, Живот, Темите на деня За още актуални новини: Последвайте ни в Google News
Проф Радостина Александрова от БАН обяснява какво знаем за новата
...... заболявания става критичен фактор.Международните космически агенции вече работят по подобряване на биологичната сигурност на космическите станции и разработват нови протоколи за мониторинг на микробиологичната обстановка.
Близо две трети от населението на света живее в страни
...... и Палестина етнорелигиозният национализъм и екстремизмът се пресичат, за да подкопаят религиозната свобода. Други 24 държави, включително Беларус, Чили, Индонезия и Кения, са „под наблюдение“.
НОВО ДЕЛХИ AP — От Андите до Хималаите нова вълна
...... мощна роля в целия свят“, каза Rajbhandari.———Журналистите на Associated Press Франклин Брисеньо в Лима, Перу и Ниранджан Шреста в Катманду, Непал, допринесе за този доклад.
За поредна година община Свищов със съдействието на Домашен социален
...... силните сме длъжни да подкрепяме в немощите им слабите. С това, което по инициатива на г-н Генчев днес правим, ние успяваме да покажем именно това.“.
Преди 15 години Иън Айърс и Бари Нейлбъф публикуват книга
...... много богатите хора, които са могли да получат по-добра сделка за кредитиране. В една от рецензиите на книгата се казва: „Не опитвайте това у дома“.
Като част от Unilever производителят на сладолед Magnum който планира
...... нови популярни вкусове, включително дубайския шоколад. NotCo е съдействала на Kraft Heinz в разработването на растителни алтернативи на макароните със сирене, резените сирене и майонезата.
Милиони хора по света насочиха поглед към небето снощи когато
...... часа, като пълната фаза бе видима малко над час в зависимост от местоположението.Следващото лунно затъмнение ще бъде на 28 август 2026 година.Вижте повече в нашата :
По света съществуват няколко добре познати горещи точки на дълголетието
...... продължи до юни 2026 г. Учените се надяват чрез него да открият по-ясни връзки между дълголетието и местните особености на обществото и културата във Финландия.
По света съществуват няколко добре познати горещи точки на дълголетието
...... продължи до юни 2026 г. Учените се надяват чрез него да открият по-ясни връзки между дълголетието и местните особености на обществото и културата във Финландия.
Кейптаун е обявен за най добрия град в света според Time
...... Африка 4. Ню Йорк, САЩ 5. Копенхаген, Дания 6. Барселона, Испания 7. Единбург, Шотландия 8. Мексико Сити, Мексико 9. Лондон, Англия 10. Шанхай, Китай
Израелски археолози направиха откритие което може би представлява най старият известен
...... Вие можете да допринесете за нашия стремеж към истината, неприкривана от финансови зависимости. Можете да помогнете единственият поръчител на съдържание да сте вие – читателите.
Израелски археолози направиха откритие което може би представлява най старият известен
...... посветени на достойнството и грижата за своите възрастни“, допълни той.Изследователите споделят, че по-нататъшни разкопки могат да разкрият повече подробности за разположението и функцията на сградата.
От дълбините на океаните до върховете на планините – нашата
...... все още има факти, които остават непознати за мнозина. Например: знаехте ли, че Хималаите все още растат?Вижте някои от най-невероятните факти за нашата планета в
Еврейското население на света все още не е се възстановило
...... на еврейския музей на Холокоста в САЩ трябва да преразгледа ролята си Ерик Адамс подписва изпълнителна заповед, приемаща дефиницията на групата за възпоменание на Холокоста
Един на всеки шест души по света се чувства самотен
...... се стимулират връзките от всички възрасти.„Това не е проблем за тези, които са самотни или изолирани. Това е проблем за цялото общество.“, допълват шведските власти.
Александър Зверев заяви че е настроен оптимистично преди Уимбълдън Световният
...... започне участието си на Уимбълдън с мач срещу Артур Риндеркнеш. При победа, следващият опонент на германеца ще бъде Пабло Кареньо Буста или квалификанта Крис Родеш.
Голяма сума от богатството се спусна в Венеция Италия през
...... от 2023 г. (41 милиона долара), според Forbes и R&B Singer Usher, който оглави шоуто на полувремето Super Bowl 2024, също бяха в ATT ATT
Милиони хора по света са се възползвали от помощ от
...... помощ за развитие, докато 15,1 милиона са получили достъп до модерни мрежи за енергоснабдяване или са се възползвали в по-голяма степен от него, съобщи ГДМС.
В света има два различни типа хора тези които искат
...... В света има два различни типа хора: тези, които искат да знаят, и онези, които искат да вярват. Фридрих Ницше
TD Кметът на Благоевград и министърът на труда и социалната политика
...... областният управител Георги Динев, председателят на Общински съвет Антоанета Богданова, директорът на РД "Социално подпомагане“ Виктория Харалампиева, представители на държавни и местни институции, социални работници.
Кметът на Благоевград и министърът на труда и социалната политика
...... областният управител Георги Динев, председателят на Общински съвет Антоанета Богданова, директорът на РД "Социално подпомагане“ Виктория Харалампиева, представители на държавни и местни институции, социални работници.
Министърът на труда и социалната политика Борислав Гуцанов ще даде
...... по НПВУ за реновирането на 81 дома за стари хора и създаването на 254 нови услуги за хора с увреждания, включително и за резидентна грижа.
Утре 19 юни от 10 00 часа кметът на община Благоевград
...... (НПВУ). Целта на проекта е Домът да постигне пълно съответствие с изискванията на стандартите за качество на резидентната грижа за възрастни хора в надтрудоспособна възраст.
TD Утре 19 юни от 10 00 часа кметът на община Благоевград
...... (НПВУ). Целта на проекта е Домът да постигне пълно съответствие с изискванията на стандартите за качество на резидентната грижа за възрастни хора в надтрудоспособна възраст.
Утре 19 юни от 10 00 часа кметът на община Благоевград
...... (НПВУ). Целта на проекта е Домът да постигне пълно съответствие с изискванията на стандартите за качество на резидентната грижа за възрастни хора в надтрудоспособна възраст.
Визуалната изложба Изкуство с увреждания е посветена на таланта и
...... посока, чрез четири интерактивни инсталации.Времето, което посетителите прекарват, за да се насладят напълно на „Изкуство с увреждания“ е в рамките на час, час и половина.
Според доклад на FEDIAF организация която представлява европейската индустрия
...... по-многобройни, а продуктите - по-претенциозни. Безопасно и приятно пътуване за вашите домашни любимци и животни Как да организираме превоза им при пътувания на по-далечни дестинации?
Легендата Чарлз Баркли нарече ръководството на Ню Йорк Никс най глупавите
...... да нямаш план… Три треньора ти отказаха. Трябва да имаш план, човече. Те нямат план и не знам какво ще се случи сега", коментира Баркли.
в първия понеделник сутринта през юни Джоселин Уокър изчака колата
...... това или в някоя от нашите статии. Ето някои. И ето нашия имейл :. Следвайте секцията за мнение на New York Times на , и.
Хората чиито разполагаеми финансови средства с изключение на основното им
...... богатството и паралелното нарастване на неравенството доведоха до многобройни дебати през последните години за това как да бъдат накарани най-богатите хора да плащат по-високи данъци.
Златото е убежище за инвеститорите особено за тези разполагащи с
...... Икономическата политика на президента на САЩ е въможно да доведе не само до търговска, но и до валутна война, коментираха Макс Баклаян и Стоян Панчев
Климатичните промени причинени от човека са добавили средно 30 дни
...... от изкопаеми горива променят ежедневните ни температурни промени – и излагат на риск милиарди хора", зяяви д-р Кристина Дал, вицепрезидент по науката в Climate Central.
Султанът на Бруней Хасанал Болкиах е в добро здравословно състояние
...... разкошен начин на живот, който преди години го нареди сред най-богатите хора в света. Към 2023 г. състоянието му се оценява на 50 милиарда долара.
СЗО предупреждава за критична неподготвеност и нарастваща резистентност към лекарстваГъбични
...... не очакват истинска гъбична пандемия в близко бъдеще, но предупреждават, че ако не се вземат мерки сега, тези инфекции "ще причинят много проблеми с времето".
айсбергът Goeth Най големият айсберг в света A23 се раздробява
...... от айсберг заливат океанската повърхност близо до главния Берг, създавайки сцена, напомняща на тъмна звездна нощ“, пише представители на космическата агенция, съобщи Live Science. Мо
И още една страна на безпрецедентната ситуация с продължилата шест
...... на хора, които доброволно помагат на други в нужда."И IT секторът се включи, като разработи специално приложение за споделено пътуване. В него се регистрираха стотици.





,fit(480:270))
















)


&format=webp)











,fit(968:545)&16:56:16)